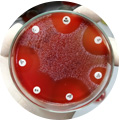

آزمایشگاه جامع تحقیقاتی ژنومیکس به عنوان آزمایشگاه برتر پژوهشهای کاربردی کشور در سالهای ۱۴۰۲ و ۱۴۰۳، با هدف تلفیق آموزش، پژوهش و خدمات تخصصی فعالیت میکند. این مرکز مرجع رسمی مدرسه ملی زیستفناوری ایران بوده و بهعنوان بازوی علمی و پژوهشی مؤسسه مطالعاتی نسیم در حوزه سرطان شناخته میشود.
تجهیزات مدرن و فناوریهای روز ژنومیکس برای انجام پژوهشهای دقیق و قابل اعتماد.
از کارآموزی تخصصی و همکاری در پایاننامهها تا اجرای طرحهای پژوهشی و تستهای تحقیقاتی.



در تمامی آزمایش ها و تحقیقات از کیت های دارای اصالت و حساسیت بالا استفاده می شود


تمامی تجهیزات تخصصی ژنومیکس، دستگاه ها و لوازم 2023 و 2024 به بعد است
به صورت دوره ای، جهت پایش و ارزیابی سطح آگاهی کارکنان، دوره های ضروری برگزار می شود
